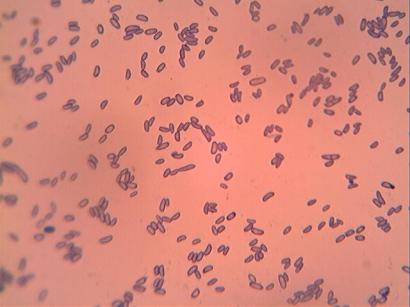

OK…So I really hope at least one of the Co-Op students is enjoying this course as much as I am! Long after the students have gone home, I’m looking at specimen under the microscope! And as we speak, I am trying another way to grow mold, since our first attempt was a bit futile! (Come to find out, the bread we buy at the grocery store generally has too many preservatives in it to cooperate when we need it to! I would recommend using bakery bread or home made bread without all the preservatives.)
Experiment 4.1 – Phylum Basidiomycota
The day before doing experiment 4.1, we set up a mushroom to make a spore print. (You can find instructions in the previous Module 4 post or on Applie’s Blog.) Because the gills were a light color, we choose black paper. Here’s what we got:
Oops….wrong photo! But you can see the similarity:
Who knew….Mushroom Spores – Nature’s Fireworks! This print was only 1/2 the cap; we weren’t sure of the spore color, so we did our print half-way on white paper and half-way on black paper.
Now back to Experiment 4.1. As we were making our spore print on paper, we made a spore print the same way on a microscope slide. This way we had a lot more spores on the slide than we would have just tapping the cap over a slide. Here are some images:
Due to the three-dimensional nature of the gill, I did a video tour of the gill. Please excuse the amateur-ish quality of the video…I haven’t figured out how to edit video yet! It’s kind of long, so feel free to fast forward through it.
Experiment 4.2 – Yeast and the Fermentation Process
These images are both at 400X
Experiment 4.3 – Molds
Why is it, that when you have no need of mold, you find something in the back of your refrigerator, or the bread you bought last week has something growing on it and you must throw it out, but when you need mold….it is nowhere to be found? We did not have a good specimen to view for this experiment. I did get this shot (at 400X/stained) over the weekend, from a tiny bit of mold growing on a tomato:
Instead of trying to scrape the little bit of mold there was, I put a drop of water on the mold, then sucked it up with an eyedropper and put a drop on the slide. If I get more images, I’ll put them up later…..there’s gonna be mold on something sooner or later, right?

#1 by Shannan on October 13, 2010 - 1:25 pm
Love it!!! Very cool!!!
#2 by Margie on February 24, 2011 - 12:50 pm
Interesting, thanks!!